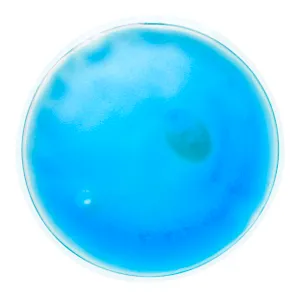
Chaufferette publicitaire - Relief | Bleu

Chaufferette publicitaire - Relief
DYN-00005681
Dès 0,53 € HT
Sans marquage
et selon quantité
Cet article est conçu pour être personnalisé avec votre logo.
Nos articles sont livrés en moyenne sous 1 à 3 semaines
selon la personnalisation choisie
Livré sous 1 à 3 semaines
selon personnalisation
Parcours devis
Faites-en plus avec un compte :
- Validez vos demandes de devis et vos commandes plus rapidement
- Enregistrez vos différentes adresses
- Accédez au suivi de vos commandes
Suivi de projet
Prix unitaire :
Total HT
0,00€
Description
Chaufferette transparente réutilisable avec gel coloré.
Caractéristiques
Parce que le choix du meilleur article se trouve parfois dans les détails, voici les caractéristiques de Chaufferette publicitaire - Relief.
| Référence Interne | DYN-00005681 |
|---|---|
| Dimensions article | ø100×10 mm |
| Matière | Plastique |
| Matière principale | Plastique |
| Pays d'origine | Chine |
| Poids net | 64 g |
Tarifs dégressifs
Profitez des meilleurs prix dégressifs sur votre série de Chaufferette publicitaire - Relief publicitaire
Nos tarifs professionnels sont optimisés selon les quantités souhaitées. Si votre demande sort du cadre de quantité du tableau ci-dessous, contactez-nous ou demandez-nous un devis personnalisé ! Une offre aux meilleures conditions vous sera envoyée sous 24h tenant compte de la personnalisation souhaitée (votre logo ou votre design).
Tarifs dégressifs de l'article sans marquage
Marquages disponibles
Marquages publicitaires disponibles pour Chaufferette publicitaire - Relief
Ce produit issu de notre gamme de goodies et objets publicitaires Chaufferettes & bouillotes est conçu pour être personnalisé avec différentes techniques de marquages publicitaires.
Stocks disponibles